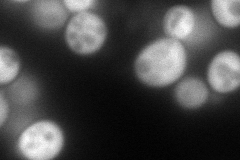
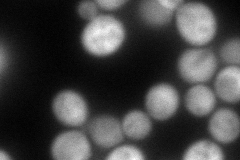

View description
Putative protein of unknown function; the authentic, non-tagged protein is detected in highly purified mitochondria in high-throughput studies
Localization:
Intensity:
Fold change:
Significance:
-
C’ GFP library in SD

mitochondria21.65 -
N' NOP1pr-GFP in SD
cytosol160.854 -
N' TEF2pr-mCherry in SD
cytosol146.341 -
N' NATIVEpr-GFP in SD

punctate24.0827 -
N' TEF2pr-VC and Cyto-VN in SD

cytosol29.9657 -
C’ GFP library in SD+DTT

mitochondria19.910.91No -
C’ GFP library in SD+H2O2

mitochondria23.161.06No -
C’ GFP library in Starvation Media

mitochondria29.141.34Yes -
C’ GFP library on the background of Pup2-DaMP

mitochondria -
C’ GFP library on the background of CCT mutant

mitochondria19.67450.908263No
